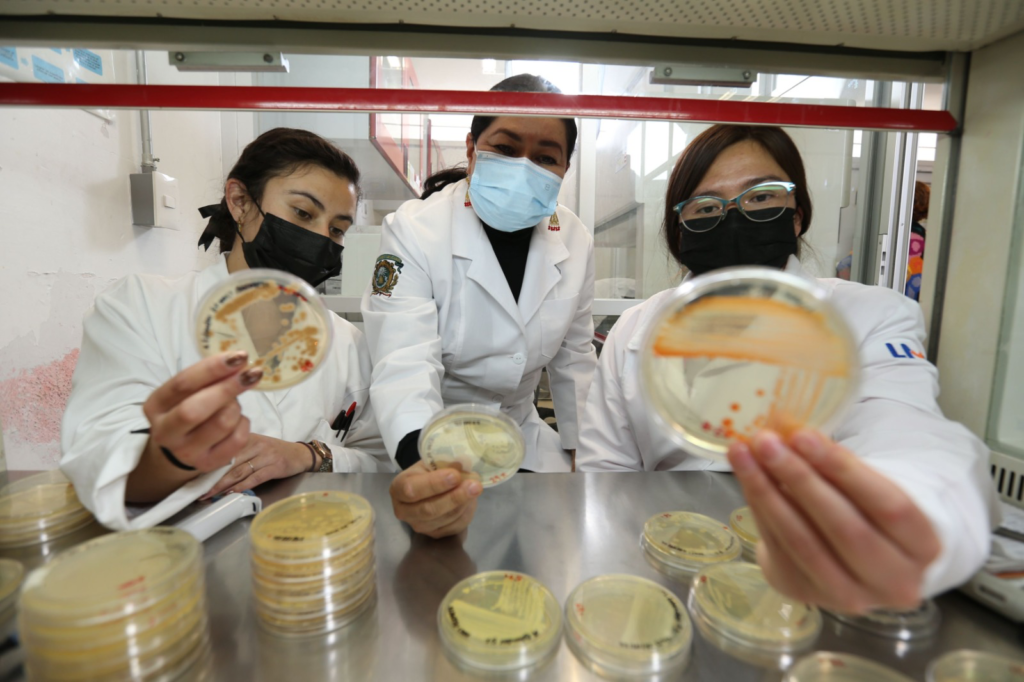

• Ramírez Durán cuenta con un equipo de trabajo compuesto por alumnas de doctorado, maestría y licenciatura.
Toluca, Méx; 03 de febrero de 2023.
Uno de los problemas más graves en el sector salud se encuentra en la multirresistencia bacteriana, la cual se debe a la adaptación de las bacterias a la presencia de fármacos utilizados para contrarrestar infecciones, lo que dificulta su tratamiento; en este sentido la investigadora Ninfa Ramírez Durán, encargada del Laboratorio de Investigación en Microbiología Médica y Ambiental en la Facultad de Medicina de la Universidad Autónoma del Estado de México (UAEMéx) actualmente estudia el uso de bacterias patógenas como posibles productoras de moléculas que a futuro puedan utilizarse en el control de infecciones.
La académica Ramírez Durán junto a su equipo de trabajo compuesto por alumnas de doctorado, maestría y licenciatura, busca por medio de actinobacterias patógenas detectar los grupos de genes biosintéticos encargados de generar las enzimas policétido sintasa (PKS) y policétidos sintetasa no ribosomales (NRPS), quienes son la base para la síntesis y fabricación de moléculas con interés en la Biomedicina.

“Si nosotros encontramos que estos genes existen en las bacterias que examinamos, entonces podemos proponerlas para ser estudiadas a un nivel genómico y confirmar las posibilidades de producción de alguna molécula de interés. El reto principal es saber si producen alguna molécula nueva y conocer la utilidad que tenga”, explicó.
A través de su proyecto de investigación “Detección de grupos de genes biosintéticos PKS y NRPS productores de metabolitos secundarios y moléculas de importancia biomédica en actinobacterias de origen clínico” , Ramírez Durán tomó muestras de casos clínicos que se pueden extraer de heridas, granulomas, sangre, aspiración bronquial de donde posteriormente fueron aisladas un grupo de bacterias conocidas como “actinobacterias” (bacterias con mayor capacidad para producir moléculas).
Los resultados hasta el momento han demostrado que, de las ciento cincuenta actinobacterias utilizadas en este estudio entre las cuales se encuentra la Nocardia brasiliensis, así como los géneros Actinomadura y Streptomyces- solamente quince han demostrado tener potencial productor de moléculas.
No obstante, todavía falta por analizar las moléculas que posiblemente estén implicadas en dicha actividad antimicrobiana.
Divulgar la ciencia para motivar a niñas y adolescentes
Además de realizar investigación y ser docente en la Facultad de Medicina, la académica Ramírez Durán y su equipo de laboratorio realizan actividades de divulgación científica con el fin de mostrar a qué se dedican las mujeres científicas y motivar a las nuevas generaciones de niñas y adolescentes que aún no saben qué carrera elegir.
Mediante la creación de espacios de acceso universal al conocimiento y la realización de actividades como exposiciones de fotografías, proyecciones de películas, concursos de cuentos y pinturas, se proponen explicar en qué consiste el campo científico y facilitar el acceso al conocimiento.
“No buscamos convencerlos, buscamos transmitir el conocimiento de una manera ligera, de una forma amable y entendible, para una persona sin importar su nivel académico, social y cultural”, concluyó.

Enlace de video
https://drive.google.com/file/d/1DgljUM4h0jEMqu5S-1Kwgmw8RAY4varm/view?usp=sharing








